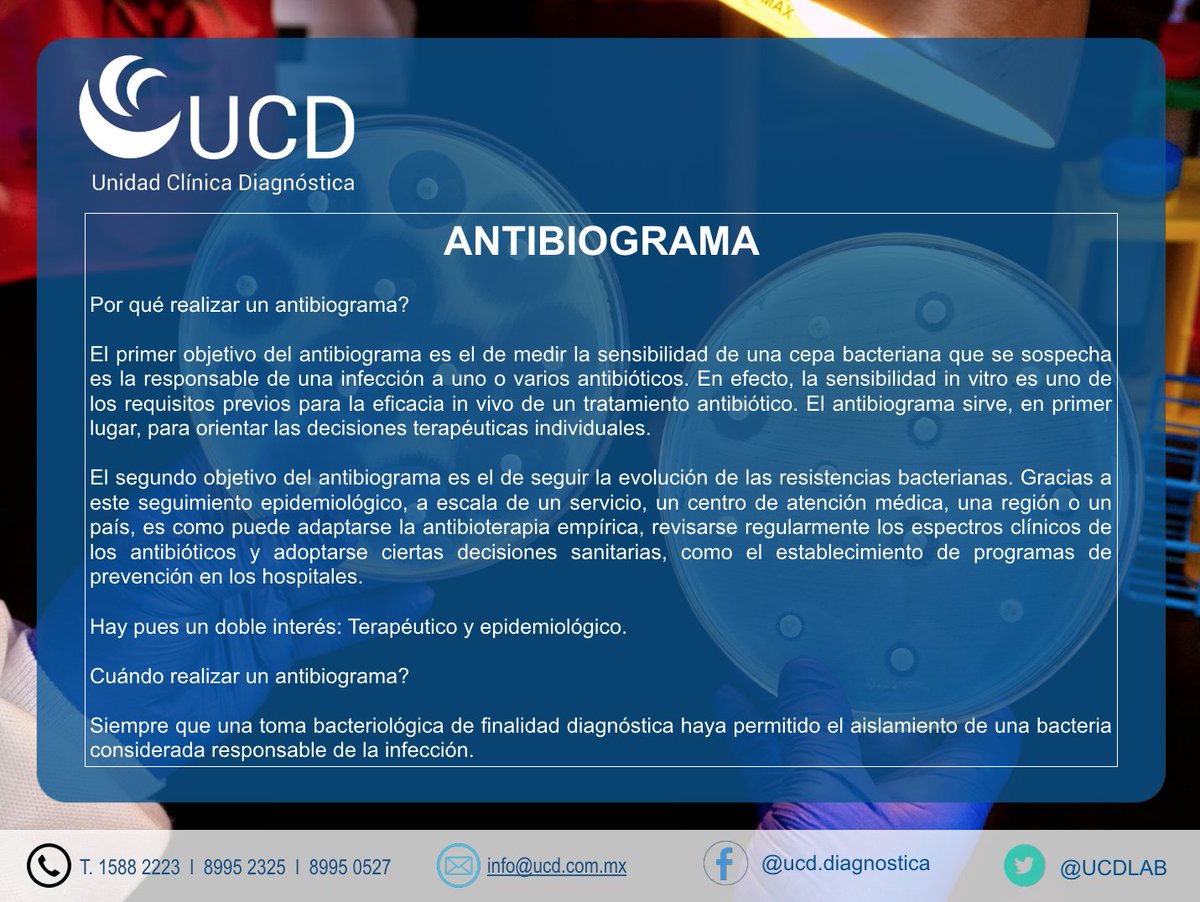
UCDLAB's tweet image.

UCD Laboratorio
@UCDLAB
Somos un laboratorio que ofrece estudios con el más alto estándar de calidad, confiabilidad y control de calidad.
You might like
United States Trends
- 1. Good Tuesday N/A
- 2. #SayonaHijaDelMal N/A
- 3. #JUNGKOOKxHUBLOT N/A
- 4. Taco Tuesday N/A
- 5. #TuesdayFeeling N/A
- 6. Coco Gauff N/A
- 7. #CatForCashEP4 N/A
- 8. $Giraffes N/A
- 9. Wexner N/A
- 10. #10Feb N/A
- 11. Ron Johnson N/A
- 12. Randy Fine N/A
- 13. Yayo N/A
- 14. Ja Rule N/A
- 15. Murda N/A
- 16. Maxwell N/A
- 17. Chip Roy N/A
- 18. Bridges N/A
- 19. Stew N/A
- 20. Victoria's Secret N/A
Loading...
Something went wrong.
Something went wrong.